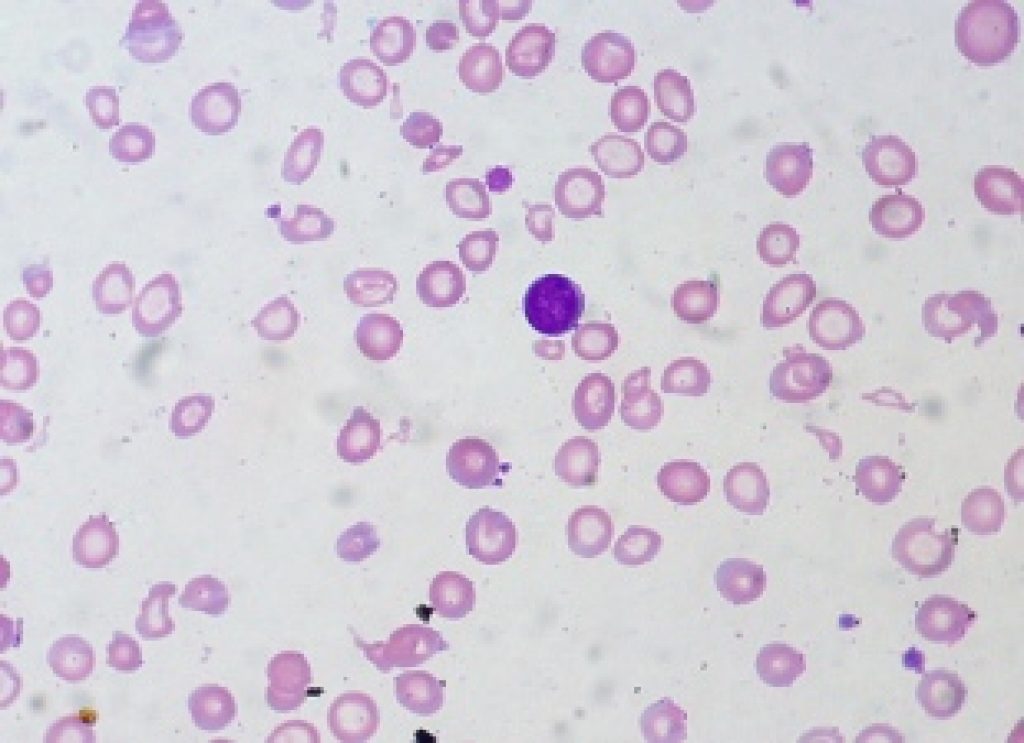

Asian Scientist (Aug. 26, 2013) – A team of researchers has uncovered a link between an enzyme known as Lyn and the blood disorder anemia.
Anemia describes a condition where there is a deficiency in the number or quality of red blood cells.
In their study, published in Blood, the researchers showed that the hyperactivity of the Lyn enzyme is associated with anemia. The finding could fast-track treatments for patients who suffer specific types of anemia.
New findings proving the link with the Lyn enzyme could be used in the future to fast-track treatments for patients who suffer specific types of anaemia.
The research team explored the complicated biochemistry that occurs in the body when it’s making red blood cells. The process involves a naturally occurring protein, EPO, which has gained notoriety as an illegal drug in competitive sports such as cycling.
“EPO is an important growth factor, which is produced by the kidneys and is needed in the process of turning stem cells into a healthy number of mature red blood cells,” said Associate Professor Evan Ingley, senior author of the study.
“In this study, we were particularly interested in an enzyme called Lyn, which is activated during this process and which is necessary for EPO to make red blood cells,” he said.
The research explored the effects on red blood cells if too much of the Lyn enzyme was produced.
“The red blood cells with hyperactive Lyn looked very different to normal blood cells,” said Ingley.
“There were changes to the structure of the red blood cells resulting in lower numbers of red blood cells than that needed for good health.”
He said drugs that turned off the Lyn enzyme were already available in the treatment of leukemia, therefore, these drugs can potentially be used in other diseases in which severe anemia was a problem.
The article can be found at: Slavova-Azmanova et al. (2013) Gain-Of-Function Lyn Induces Anemia: Appropriate Lyn Activity Is Essential For Normal Erythropoiesis And Epo-Receptor Signaling.
——
Source: UWA; Photo: euthman/Flickr/CC.
Disclaimer: This article does not necessarily reflect the views of AsianScientist or its staff.












